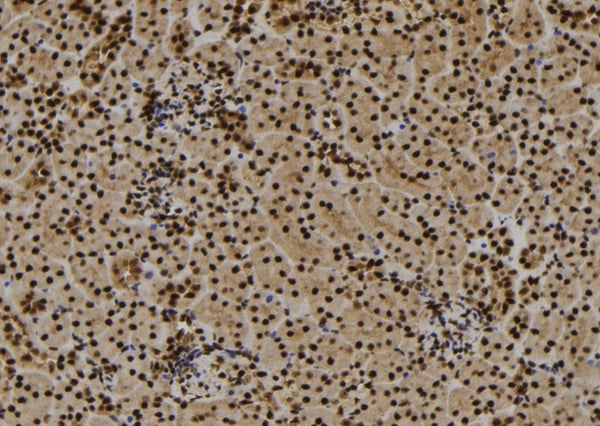
product-image-AAA326757_IHC15.jpg

Rabbit HMGB1 Polyclonal Antibody | anti-HMGB1 antibody
HMGB1 Antibody
Phosphate buffered saline, pH 7.4, 150mM NaCl, 0.02% sodium azide and 50% glycerol.
IF (Immunofluorescence)
(AAA326757 staining Hela by IF/ICC. The sample were fixed with PFA and permeabilized in 0.1% Triton X-100, then blocked in 10% serum for 45 minutes at 25 degree C. The primary antibody was diluted at 1/200 and incubated with the sample for 1 hour at 37 degree C. An Alexa Fluor 594 conjugated goat anti-rabbit IgG (H+L) Ab, diluted at 1/600, was used as the secondary antibody.)
WB (Western Blot)
(Western blot analysis of extracts of Jurkat, using HMGB1antibody. The lane on the left is treated with the antigen-specific peptide.)
IF (Immunofluorescence)
(AAA326757 staining Hela by IF/ICC. The sample were fixed with PFA and permeabilized in 0.1% Triton X-100, then blocked in 10% serum for 45 minutes at 25 degree C. The primary antibody was diluted at 1/200 and incubated with the sample for 1 hour at 37 degree C. An Alexa Fluor 594 conjugated goat anti-rabbit IgG (H+L) Ab, diluted at 1/600, was used as the secondary antibody.)
WB (Western Blot)
(Western blot analysis of extracts of various tissue sample, using HMGB1 Antibody.)
IHC (Immunohistochemistry)
(AAA326757 at 1/100 staining Mouse kidney tissue by IHC-P. The sample was formaldehyde fixed and a heat mediated antigen retrieval step in citrate buffer was performed. The sample was then blocked and incubated with the antibody for 1.5 hours at 22 degree C. An HRP conjugated goat anti-rabbit antibody was used as the secondary.)
Function: Multifunctional redox sensitive protein with various roles in different cellular compartments. In the nucleus is one of the major chromatin-associated non-histone proteins and acts as a DNA chaperone involved in replication, transcription, chromatin remodeling, V(D)J recombination, DNA repair and genome stability. Proposed to be an universal biosensor for nucleic acids. Promotes host inflammatory response to sterile and infectious signals and is involved in the coordination and integration of innate and adaptive immune responses. In the cytoplasm functions as sensor and/or chaperone for immunogenic nucleic acids implicating the activation of TLR9-mediated immune responses, and mediates autophagy. Acts as danger associated molecular pattern (DAMP) molecule that amplifies immune responses during tissue injury (PubMed:27362237). Released to the extracellular environment can bind DNA, nucleosomes, IL-1 beta, CXCL12, AGER isoform 2/sRAGE, lipopolysaccharide (LPS) and lipoteichoic acid (LTA), and activates cells through engagement of multiple surface receptors. In the extracellular compartment fully reduced HMGB1 (released by necrosis) acts as a chemokine, disulfide HMGB1 (actively secreted) as a cytokine, and sulfonyl HMGB1 (released from apoptotic cells) promotes immunological tolerance (PubMed:23519706, PubMed:23446148, PubMed:23994764, PubMed:25048472). Has proangiogdenic activity (By similarity). May be involved in platelet activation (By similarity). Binds to phosphatidylserine and phosphatidylethanolamide (By similarity). Bound to RAGE mediates signaling for neuronal outgrowth (By similarity). May play a role in accumulation of expanded polyglutamine (polyQ) proteins such as huntingtin (HTT) or TBP (PubMed:23303669, PubMed:25549101).
Subunit Structure: Interacts (fully reduced HMGB1) with CXCL12; probably in a 1:2 ratio involving two molecules of CXCL12, each interacting with one HMG box of HMGB1; inhibited by glycyrrhizin (PubMed:22370717). Associates with the TLR4:LY96 receptor complex (PubMed:20547845). Component of the RAG complex composed of core components RAG1 and RAG2, and associated component HMGB1 or HMGB2 (By similarity). Interacts (in cytoplasm upon starvation) with BECN1; inhibits the interaction of BECN1 and BCL2 leading to promotion of autophagy (PubMed:20819940). Interacts with KPNA1; involved in nuclear import (PubMed:17114460). Interacts with SREBF1, TLR2, TLR4, TLR9, PTPRZ1, APEX1, FEN1, POLB, TERT (By similarity). Interacts with IL1B, AGER, MSH2, XPA, XPC, HNF1A, TP53 (PubMed:15014079, PubMed:18250463, PubMed:18160415, PubMed:19446504, PubMed:24474694, PubMed:23063560). Interacts with CD24; the probable CD24:SIGLEC10 complex is proposed to inhibit HGMB1-mediated tissue damage immune response (PubMed:19264983). Interacts with THBD; prevents HGMB1 interaction with ACER/RAGE and inhibits HGMB1 proinflammatory activity (PubMed:15841214). Interacts with HAVCR2; impairs HMGB1 binding to B-DNA and likely HMGB1-mediated innate immume response (By similarity). Interacts with XPO1; mediating nuclear export (By similarity). Interacts with HTT (wild-type and mutant HTT with expanded polyglutamine repeat) (PubMed:23303669).
Post-translational Modifications: Phosphorylated at serine residues. Phosphorylation in both NLS regions is required for cytoplasmic translocation followed by secretion (PubMed:17114460). Acetylated on multiple sites upon stimulation with LPS (PubMed:22801494). Acetylation on lysine residues in the nuclear localization signals (NLS 1 and NLS 2) leads to cytoplasmic localization and subsequent secretion (By similarity). Acetylation on Lys-3 results in preferential binding to DNA ends and impairs DNA bending activity (By similarity). Reduction/oxidation of cysteine residues Cys-23, Cys-45 and Cys-106 and a possible intramolecular disulfide bond involving Cys-23 and Cys-45 give rise to different redox forms with specific functional activities in various cellular compartments: 1-fully reduced HMGB1 (HMGB1C23hC45hC106h), 2-disulfide HMGB1 (HMGB1C23-C45C106h) and 3-sulfonyl HMGB1 (HMGB1C23soC45soC106so). Poly-ADP-ribosylated by PARP1 when secreted following stimulation with LPS (By similarity). In vitro cleavage by CASP1 is liberating a HMG box 1-containing peptide which may mediate immunogenic activity; the peptide antagonizes apoptosis-induced immune tolerance (PubMed:24474694). Can be proteolytically cleaved by a thrombin:thrombomodulin complex; reduces binding to heparin and proinflammatory activities (By similarity).
Similarity: HMG box 2 mediates proinflammatory cytokine-stimulating activity and binding to TLR4 (PubMed:12765338, PubMed:20547845). However, not involved in mediating immunogenic activity in the context of apoptosis-induced immune tolerance (PubMed:24474694).The acidic C-terminal domain forms a flexible structure which can reversibly interact intramolecularily with the HMG boxes and modulate binding to DNA and other proteins (PubMed:23063560). Belongs to the HMGB family.
NCBI and Uniprot Product Information
Predicted: 25 kDa
Customer Reviews
Loading reviews...
Share Your Experience
Similar Products
Product Notes
The HMGB1 hmgb1 (Catalog #AAA326757) is an Antibody produced from Rabbit and is intended for research purposes only. The product is available for immediate purchase. The HMGB1 Antibody reacts with Human, Mouse, Rat and may cross-react with other species as described in the data sheet. AAA Biotech's HMGB1 can be used in a range of immunoassay formats including, but not limited to, ELISA, ICC (Immunocytochemistry), IF (Immunofluorescence), IHC (Immunohistochemistry), WB (Western Blot). Researchers should empirically determine the suitability of the HMGB1 hmgb1 for an application not listed in the data sheet. Researchers commonly develop new applications and it is an integral, important part of the investigative research process. It is sometimes possible for the material contained within the vial of "HMGB1, Polyclonal Antibody" to become dispersed throughout the inside of the vial, particularly around the seal of said vial, during shipment and storage. We always suggest centrifuging these vials to consolidate all of the liquid away from the lid and to the bottom of the vial prior to opening. Please be advised that certain products may require dry ice for shipping and that, if this is the case, an additional dry ice fee may also be required.Precautions
All products in the AAA Biotech catalog are strictly for research-use only, and are absolutely not suitable for use in any sort of medical, therapeutic, prophylactic, in-vivo, or diagnostic capacity. By purchasing a product from AAA Biotech, you are explicitly certifying that said products will be properly tested and used in line with industry standard. AAA Biotech and its authorized distribution partners reserve the right to refuse to fulfill any order if we have any indication that a purchaser may be intending to use a product outside of our accepted criteria.Disclaimer
Though we do strive to guarantee the information represented in this datasheet, AAA Biotech cannot be held responsible for any oversights or imprecisions. AAA Biotech reserves the right to adjust any aspect of this datasheet at any time and without notice. It is the responsibility of the customer to inform AAA Biotech of any product performance issues observed or experienced within 30 days of receipt of said product. To see additional details on this or any of our other policies, please see our Terms & Conditions page.Item has been added to Shopping Cart
If you are ready to order, navigate to Shopping Cart and get ready to checkout.